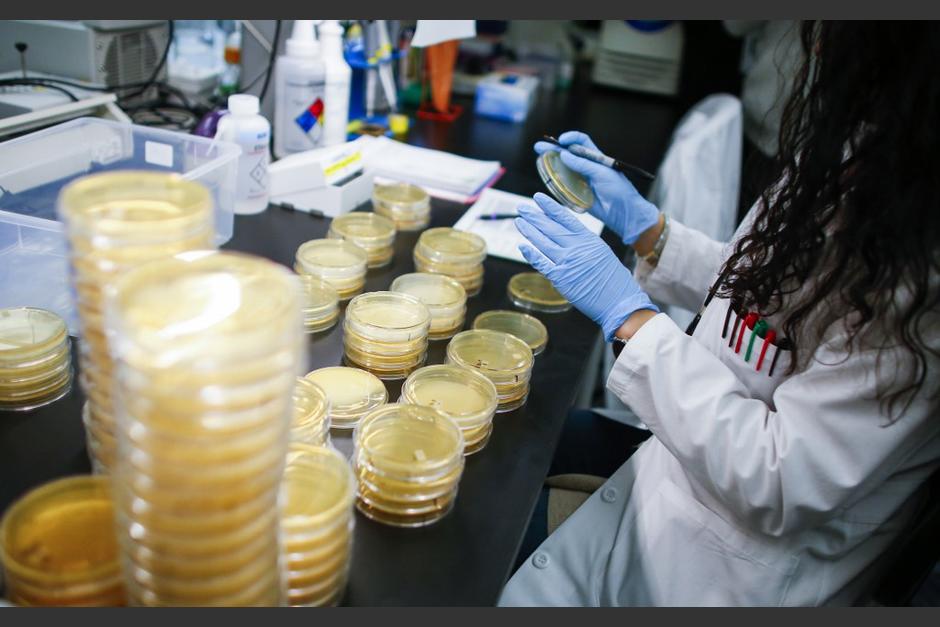
México está en alerta por la presencia del virus encontrado en tres personas que regresaron de Italia. (Foto: AFP)

México se convirtió en el segundo país latinoamericano alcanzado por el nuevo coronavirus (COVID-19), que suma ya tres casos importados de Italia y, probablemente, contagiados por una misma persona, informó el ministerio de Salud.
Se trata de tres hombres, dos en ciudad de México y uno más en Sinaloa, que participaron días atrás de un congreso en la ciudad italiana de Bérgamo (al norte), donde tuvieron contacto con un hombre de la localidad que habría contraído el virus en Malasia.
"Hasta este momento tenemos tres casos confirmados del nuevo coronavirus. Probablemente, los tres se contagiaron de una misma fuente. Los tres son casos importados", dijo en rueda de prensa José Luis Alomía, director general de epidemiología del ministerio de Salud.
Mientras tanto, los insumos de higiene y protección se agotan en supermercados y farmacias de ese país.
#Video Ante la falta de cubre bocas que se está presentando en las farmacias, en calles del Centro Histórico han comenzado a aparecer revendedores de este artículo. El precio va de los 3 pesos los sencillos, 50 los industriales y hasta 480 pesos un paquete pic.twitter.com/gMoSOjhDlM
Hasta este viernes, Brasil era el único país de América Latina en registrar un caso de coronavirus, surgido en China y que se expande por el mundo, incluyendo Estados Unidos, que informó tres casos de origen desconocido.
Esto dijeron las autoridades mexicanas:
El último caso reportado en la región es el de un hombre de 59 años que se encuentra en la capital mexicana, y que estuvo en el norte de Italia, la zona más afectada por la propagación del virus en ese país. Las autoridades no detallaron si se encuentra hospitalizado.
Más temprano se habían informado los casos de contagio de un residente de ciudad de México, de 35 años, hospitalizado en el Instituto Nacional de Enfermedades Respiratorias (INER); y el de un hombre de 41 años, originario del estado de Hidalgo que voló desde la capital mexicana a Culiacán, Sinaloa, donde se encuentra aislado en un hotel.
Italia es el país más afectado en Europa por el COVID-19, con 17 muertos y más de 650 infectados.
- TE PUEDE INTERESAR: